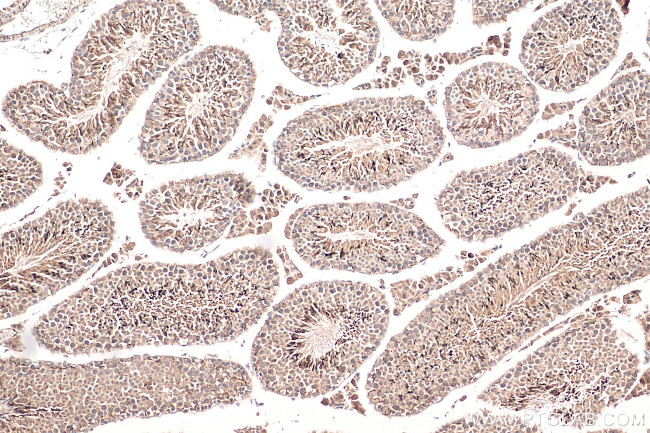
EMB Antibody in Immunohistochemistry (Paraffin) (IHC (P))

Search
Proteintech
EMB Polyclonal Antibody
{{$productOrderCtrl.translations['antibody.pdp.commerceCard.promotion.promotions']}}
{{$productOrderCtrl.translations['antibody.pdp.commerceCard.promotion.viewpromo']}}
{{$productOrderCtrl.translations['antibody.pdp.commerceCard.promotion.promocode']}}: {{promo.promoCode}} {{promo.promoTitle}} {{promo.promoDescription}}. {{$productOrderCtrl.translations['antibody.pdp.commerceCard.promotion.learnmore']}}
产品信息
13946-1-AP
种属反应
宿主/亚型
分类
类型
抗原
偶联物
形式
浓度
规格
纯化类型
保存液
内含物
保存条件
运输条件
产品详细信息
Immunogen sequence: MRALPGLLE ARARTPRLLL LQCLLAAARP SSADGSAPDS PFTSPPLREE IMANNFSLES HNISLTEHSS MPVEKNITLE RPSNVNLTCQ FTTSGDLNAV NVTWKKDGEQ LENNYLVSAT GSTLYTQYRF TIINSKQMGS YSCFFREEKE QRGTFNFKVP ELHGKNKPLI SYVGDSTVLT CKCQNCFPLN WTWYSSNGSV KVPVGVQMNK YVINGTYANE TKLKITQLLE EDGESYWCRA LFQLGESEEH IELV (1-253 aa encoded by BC059398)
靶标信息
Embigin is a 327 amino acid regulatory protein belonging to the immunoglobulin superfamily class of CAMs, and has two Ig-like (immunoglobulin-like) V- type domains. In situ hybridization analysis shows that Embigin has specific carbohydrate epitopes and plays an important role in early postimplantation embryogenesis. A highly glycosylated transmembrane glycoprotein, Embigin acts as a regulator of cell/ECM interactions during development and homeostasis of normal adult tissues. Transfection studies suggest its role in promotion of integrin-mediated cell-substratum adhesion. Widely expressed in most of the tissues and embryonal carcinoma cells, prostate and mammary cancer cell lines, it may also help in the classification of human carcinomas.
仅用于科研。不用于诊断过程。未经明确授权不得转售。
篇参考文献 (0)
生物信息学
蛋白别名: Embigin; embigin homolog; glycoprotein 70; Teratocarcinoma glycoprotein Gp-70; unnamed protein product
基因别名: AL022799; EMB; GP70
UniProt ID: (Human) Q6PCB8, (Mouse) P21995
Entrez Gene ID: (Human) 133418, (Mouse) 13723